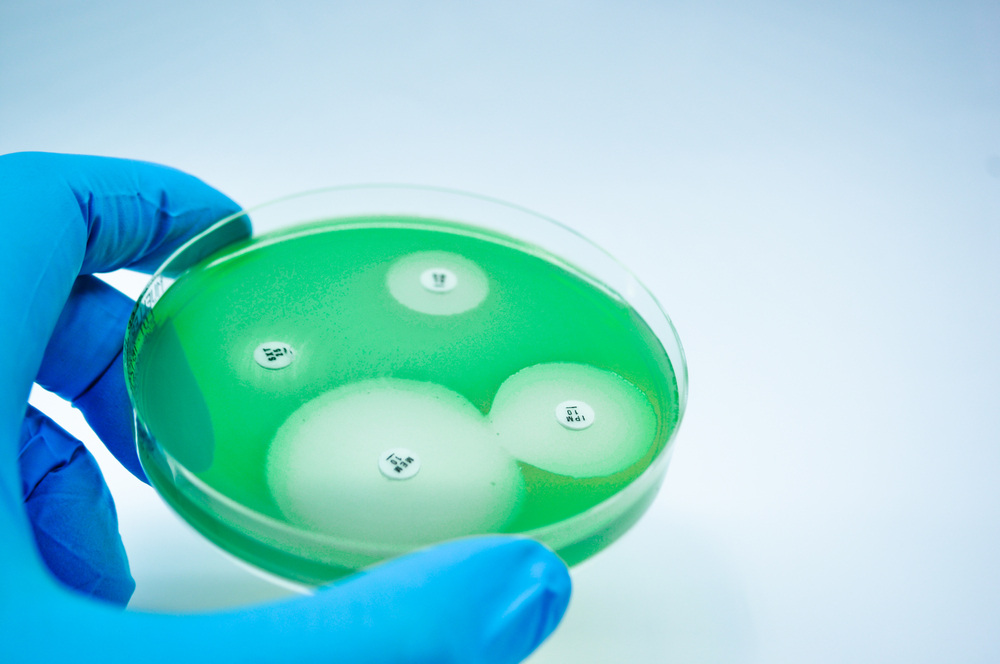

Синегнойная палочка – причина очень серьезных заболеваний, особенно у пациентов со слабым иммунитетом. Синегнойная палочка – самая частая причина внутригоспитальных инфекций у пациентов, находящихся на стационарном лечении одну неделю и более. О симптомах и лечении данной патологии читайте ниже.
Симптомы синегнойной инфекции

В зависимости от того, какой орган или система были поражены, развиваются соответствующие заболевания:
- Респираторный тракт – пневмония;
- Кровеносное русло – бактериемия;
- Сердце – эндокардит;
- Центральная нервная система – менингит, абсцессы головного мозга;
- Уши – средний и/или наружный отит;
- Глаза – бактериальный кератит, эндофтальмит;
- Кости и суставы – остеомиелит;
- Желудочно-кишечный тракт – диарея, энтерит, энтероколит;
- Мочеполовая система – пиелонефрит, цистит;
- Кожа – гангренозная эктима.
Рассмотрим особенности симптоматики по каждой системе:
- Эндокардит: лихорадка, шумы в сердце, положительный посев крови на синегнойную палочку. Кожные симптомы: пятна Рота, узелки Ослера, кровоизлияния. Увеличение селезенки (спленомегалия).
- Пневмония: кашель, хрипы, лихорадка, бледность и цианоз, гипоксия, иногда шок.
- ЖКТ: лихорадка, признаки обезвоживания, расстройства желудка и кишечника, признаки перитонита.
- Кожа и мягкие ткани: кровоизлияния и зоны некроза, окруженные эритемой (участком покрасневшей кожи), подкожные узелки, абсцессы, целлюлит, фасциит.
- Опорно-двигательный аппарат: боль и уменьшение объема движения в зоне поражения.
- Поражения глаз: отек века, конъюнктивит, слезотечение.
- Наружный отит: красный, отекший, воспаленный наружный слуховой проход, увеличение лимфатических узлов.
- Бактериемия: лихорадка, учащенные дыхание и сердцебиение, падение артериального давления и шок, желтуха.
Диагностика
Лабораторные исследования
- Клинический анализ крови;
- Посев крови на стерильность;
- Анализ мочи (общий и посев);
- Посев мокроты (при пневмонии);
- Пункция и анализ спинномозговой жидкости.
Визуализирующие исследования
- Рентгенография органов грудной клетки;
- Компьютерная томография и магнитно-резонансная томография;
- Ультразвуковое исследование;
- Эхокардиография.
Другие тесты
- Бронхоскопия;
- Торакоцентез;
- Люмбальная пункция;
- Офтальмологические и ЛОР-обследования.
Лечение
Схема лечения инфекций, вызванных синегнойной палочкой, также зависит от того, какой орган поражен. Основным препаратом, в любом случае, остается антибиотик. Обычно назначают сразу 2 антибактериальных препарата, для того, чтобы не только максимально воздействовать на синегнойную палочку, но и уничтожить другие возможные патогенные бактерии, особенно это актуально в тех случаях, когда пациент подхватил синегнойную палочку в клинике, уже получая лечение от какой-то другой болезни.
Схемы назначаемых препаратов при разных проявлениях синегнойной инфекции:
- Эндокардит – высокие дозы аминогликозидов + пенициллин или цефалоспорин широкого спектра действия. Лечение продолжается до шести недель.
- Пневмония – лечение начинается с 2 антибиотиков, по мере улучшения состояния больного один антибиотик отменяют.
- Бактериемия – из-за опасности и тяжести процесса антибактериальное лечение назначают еще до того, как придут результаты посева крови. Больной получает аминогликозид + пенициллин или цефалоспорин широкого спектра действия, иногда один из препаратов меняют на фторхинолон (например, ципрофлоксацин) или рифампицин.
- Менингит – препаратом выбора является цефтазидим, к которому подключают аминогликозид. Антибиотикотерапия длится не менее двух недель.
- Поражение ушей – обычно назначают сочетание антибиотика и кортикостероида (например, метипред).
- Поражение глаз – конъюнктивиты и изъязвления лечатся местными антибиотиками (аминогликозиды в каплях). Закапывать капли в глаза нужно каждые 30-60 минут. При тяжелых поражениях дополнительно назначаются уколы антибиотика в орбиту (в мягкие ткани рядом с глазом) и антибиотик перорально.
- Поражение мочеполовой системы – в основном, назначаются аминогликозиды и фторхинолоны в таблетках. Обычно для успешного лечения хватает одного антибиотика, главное, правильно его подобрать в начале терапии. В случае невосприимчивости инфекции к этим препаратам, больному назначают цефалоспорины, карбапенемы, пенициллины.
- Поражения желудочно-кишечного тракта – антибиотик и регидратационная терапия (капельницы с физраствором, глюкозой и витаминами) успешно справляются с болезнью.
- Кожа и мягкие ткани – пациентам назначается схема из двух антибиотиков, как местно (на участки пораженной кожи), так и в таблетках или уколах.
Хирургическое лечение
- Следует извлечь все зонды и катетеры из больного и заменить их на новые (при необходимости), если есть подозрение, что заражение произошло через них.
- Глубокая хирургическая обработка всех ран, которые могут быть инфицированы синегнойной палочкой. В некоторых случаях для сохранения жизни больного может потребоваться ампутация.
- Язвы на стопах у больных диабетом должны тщательно обрабатываться, все нежизнеспособные ткани должны быть немедленно удалены.
- Тяжелые случаи отита (злокачественный наружный отит) должны лечиться не только антибиотиками, но и хирургически. ЛОР в ходе процедуры убирает все некротизированные ткани.
- В случаях поражения желудочно-кишечного тракта с развитием осложнений (перфорация кишечника, обструкция, некроз участка кишки, формирования абсцесса) проводится немедленное хирургическое вмешательство.
К какому врачу обратиться
При возникновении любого инфекционного заболевания можно обратиться на прием к терапевту или инфекционисту. В зависимости от того, какой орган поражен синегнойной палочкой, потребуется лечение у кардиолога, дерматолога, гастроэнтеролога, нефролога, уролога, офтальмолога, ЛОР-врача и других специалистов. В диагностике принимают участие врачи-рентгенологи и эндоскописты. Лечение нередко осуществляется при участии хирурга.
